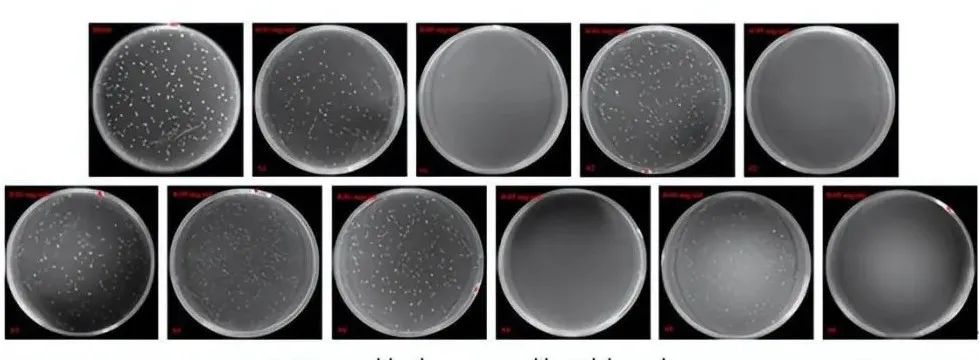

对付微生物腐蚀,来看中国科学家研发的“纳米快刀”!
2022-10-31 17:06:33
作者:王瑾 来源:科普中国
分享至:
不知道大家有没有注意过,常与海水接触的金属制品,大多难逃锈迹斑斑的厄运。这其实是厌氧微生物在作祟! 海洋环境中的微生物污损和微生物引起的腐蚀是严重的经济和安全问题。我国腐蚀造成的经济损失约占当年GDP的3.34%。而海洋腐蚀损失约占总腐蚀损失的1/3,超过7000亿元。随着海洋环境恶化,经济损失可能会增加。在腐蚀微生物中,广泛分布于缺氧环境中的硫酸盐还原菌(SRB)长期以来一直被普遍认为是导致金属材料腐蚀失效的罪魁祸首。
针对这类厌氧微生物的防治,相关学者进行了一系列研究,今年8月,中国科学院海洋研究所张盾研究员课题组为我们带来一把高效杀菌的“纳米快刀”!
二硫化钼(MoS2)是一种典型的二维材料,具有突出的活性。如图1所示,其富S头部很容易与磷脂双分子层结合,从而使MoS2可以像一把“刀”一样切入细胞膜,提取细胞膜中的磷脂双分子层,最终导致细菌死亡。
图1:(A) 杀菌过程示意图;(B) 表面吸附过程示意图
通过第一性原理计算,MoS2中的硫空位(SVs)对过硫酸盐(PMS)具有很强的吸附作用,可将其分解为具有强氧化活性的小分子物质,这些物质可以氧化分解前期提取出来的磷脂双分子层,不仅可以净化MoS2表面,还可以进一步加强杀菌作用。因此,物理切割与化学氧化相结合,使得MoS2在杀菌防污方面具有巨大的应用前景。
基于上述描述,针对SRB和铜绿假单胞菌(PA),进行了杀菌测试。如图2所示,针对SRB和PA,在PMS的辅助下,逐渐添MoS2的用量,杀菌率也随之升高。
图2:(A) 不同条件下针对SRB的杀菌性能柱状图;(B) 不同条件下针对PA的杀菌性能柱状图
此外,针对大肠杆菌(E .coli)和金黄色葡萄球菌(S. aureus),MoS2还显示出优异的杀菌效果。如图3和图4所示,只需要添加少量(5 μg/mL)的MoS2时,空白的平板说明无细菌生长,证明达到了100%的杀菌率,可谓“刀”过之处无菌可逃了!
由于海洋装备工程材料长期以来以金属为主,95%以上的材料使用钢材等金属材料,因此金属材料在海洋环境中的腐蚀问题一直是研究人员关注的焦点。EH40钢是典型的船用钢之一,SRB是缺氧环境下造成金属腐蚀失效的罪魁祸首。因此,选择EH40钢,进行MoS2的防污性能测试。如图5所示,当SRB与EH40混合时,观察到了生物膜厚度为12 μm的荧光信号,表明SRB已经在EH40上积累,这无疑会造成微生物腐蚀。当向EH40+SRB体系中添加MoS2时,几乎观察不到荧光信号。这说明,在MoS2的添加下,有效的抑制了SRB在EH40表面的聚集和附着,也就可以避免微生物腐蚀。与SRB类似,添加了MoS2后,几乎没有PA附着在EH40的表面(图8.9E-H)。MoS2优越的抑制微生物附着、进而抑制生物膜生长的行为,为抵抗海洋微生物腐蚀提供了开创性的指导。图5:14天后,EH40钢暴露于(A-D)厌氧和(E-F)好氧环境的CLSM图像 通过扫描电镜,记录下了磷脂双分子层被“刀”的过程。如图6A所示,针对SRB和PA,无论是单纯添加MoS2或是MoS2+PMS,细胞都失去原有的饱满形态,呈现出扁平和皱褶的形态,表明这些外界材料的添加对细胞造成了损伤,丧失了活力。图6 不同处理方式下的SRB和PA的扫描电镜照片(A:MoS2/SRB;B:MoS2/SRB/PMS;C:MoS2/PA;D:MoS2/PA/PMS)通过第一性原理计算,从根本上分析了杀菌机理。如图7所示,PMS和H2O均可以在MoS2表面进行自主吸附,经过一定的能垒以后,催化二者产生相应的终产物。终产物分别为SO4·-和·OH,这些物质具有强氧化性,可实现针对厌氧菌的杀菌应用,这样一来,“纳米快刀”就更锋利了。从图中可以看出,吸附PMS比吸附H2O,具有更低的能垒和更低的产物能量。因此,PMS更易吸附在MoS2表面。
图7:(A) 催化过程中涉及的关键中间体和过渡态的相对能量值;(B)(001)SVs-MoS2/PMS中关键中间体和过渡态的结构;(C)(001)SVs-MoS2/H2O中关键中间体和过渡态的结构
综上所述,通过物理损伤和化学氧化的协同作用,构建了一种基于MoS2的快速高效的厌氧杀菌系统。首先,通过物理损伤,MoS2的“刀片状”边缘插入/切割细胞膜并提取脂质。然后,通过MoS2与PMS和H2O之间的强吸附作用,产生强氧化性自由基。随后,这些积累的强氧化性自由基会攻击提取出的脂质并重新释放MoS2表面,从而恢复其抗菌能力。
通过物理损伤和化学消除的协同作用,富SVs的MoS2具有高度暴露的活性位点,构建了促进强氧化性自由基生成的平台。这些自由基的产生与细菌的密切接触,使该平台能够在各种环境中进行快速稳定的灭菌。这项工作无疑将为厌氧杀菌防污机制带来新的研究视野。
相信在这项技术得到广泛应用之后,大家在乘船出行时会更加安心,毕竟,有这样的高科技“纳米快刀”为我们扫除细菌,保驾护航呢!
免责声明:本网站所转载的文字、图片与视频资料版权归原创作者所有,如果涉及侵权,请第一时间联系本网删除。